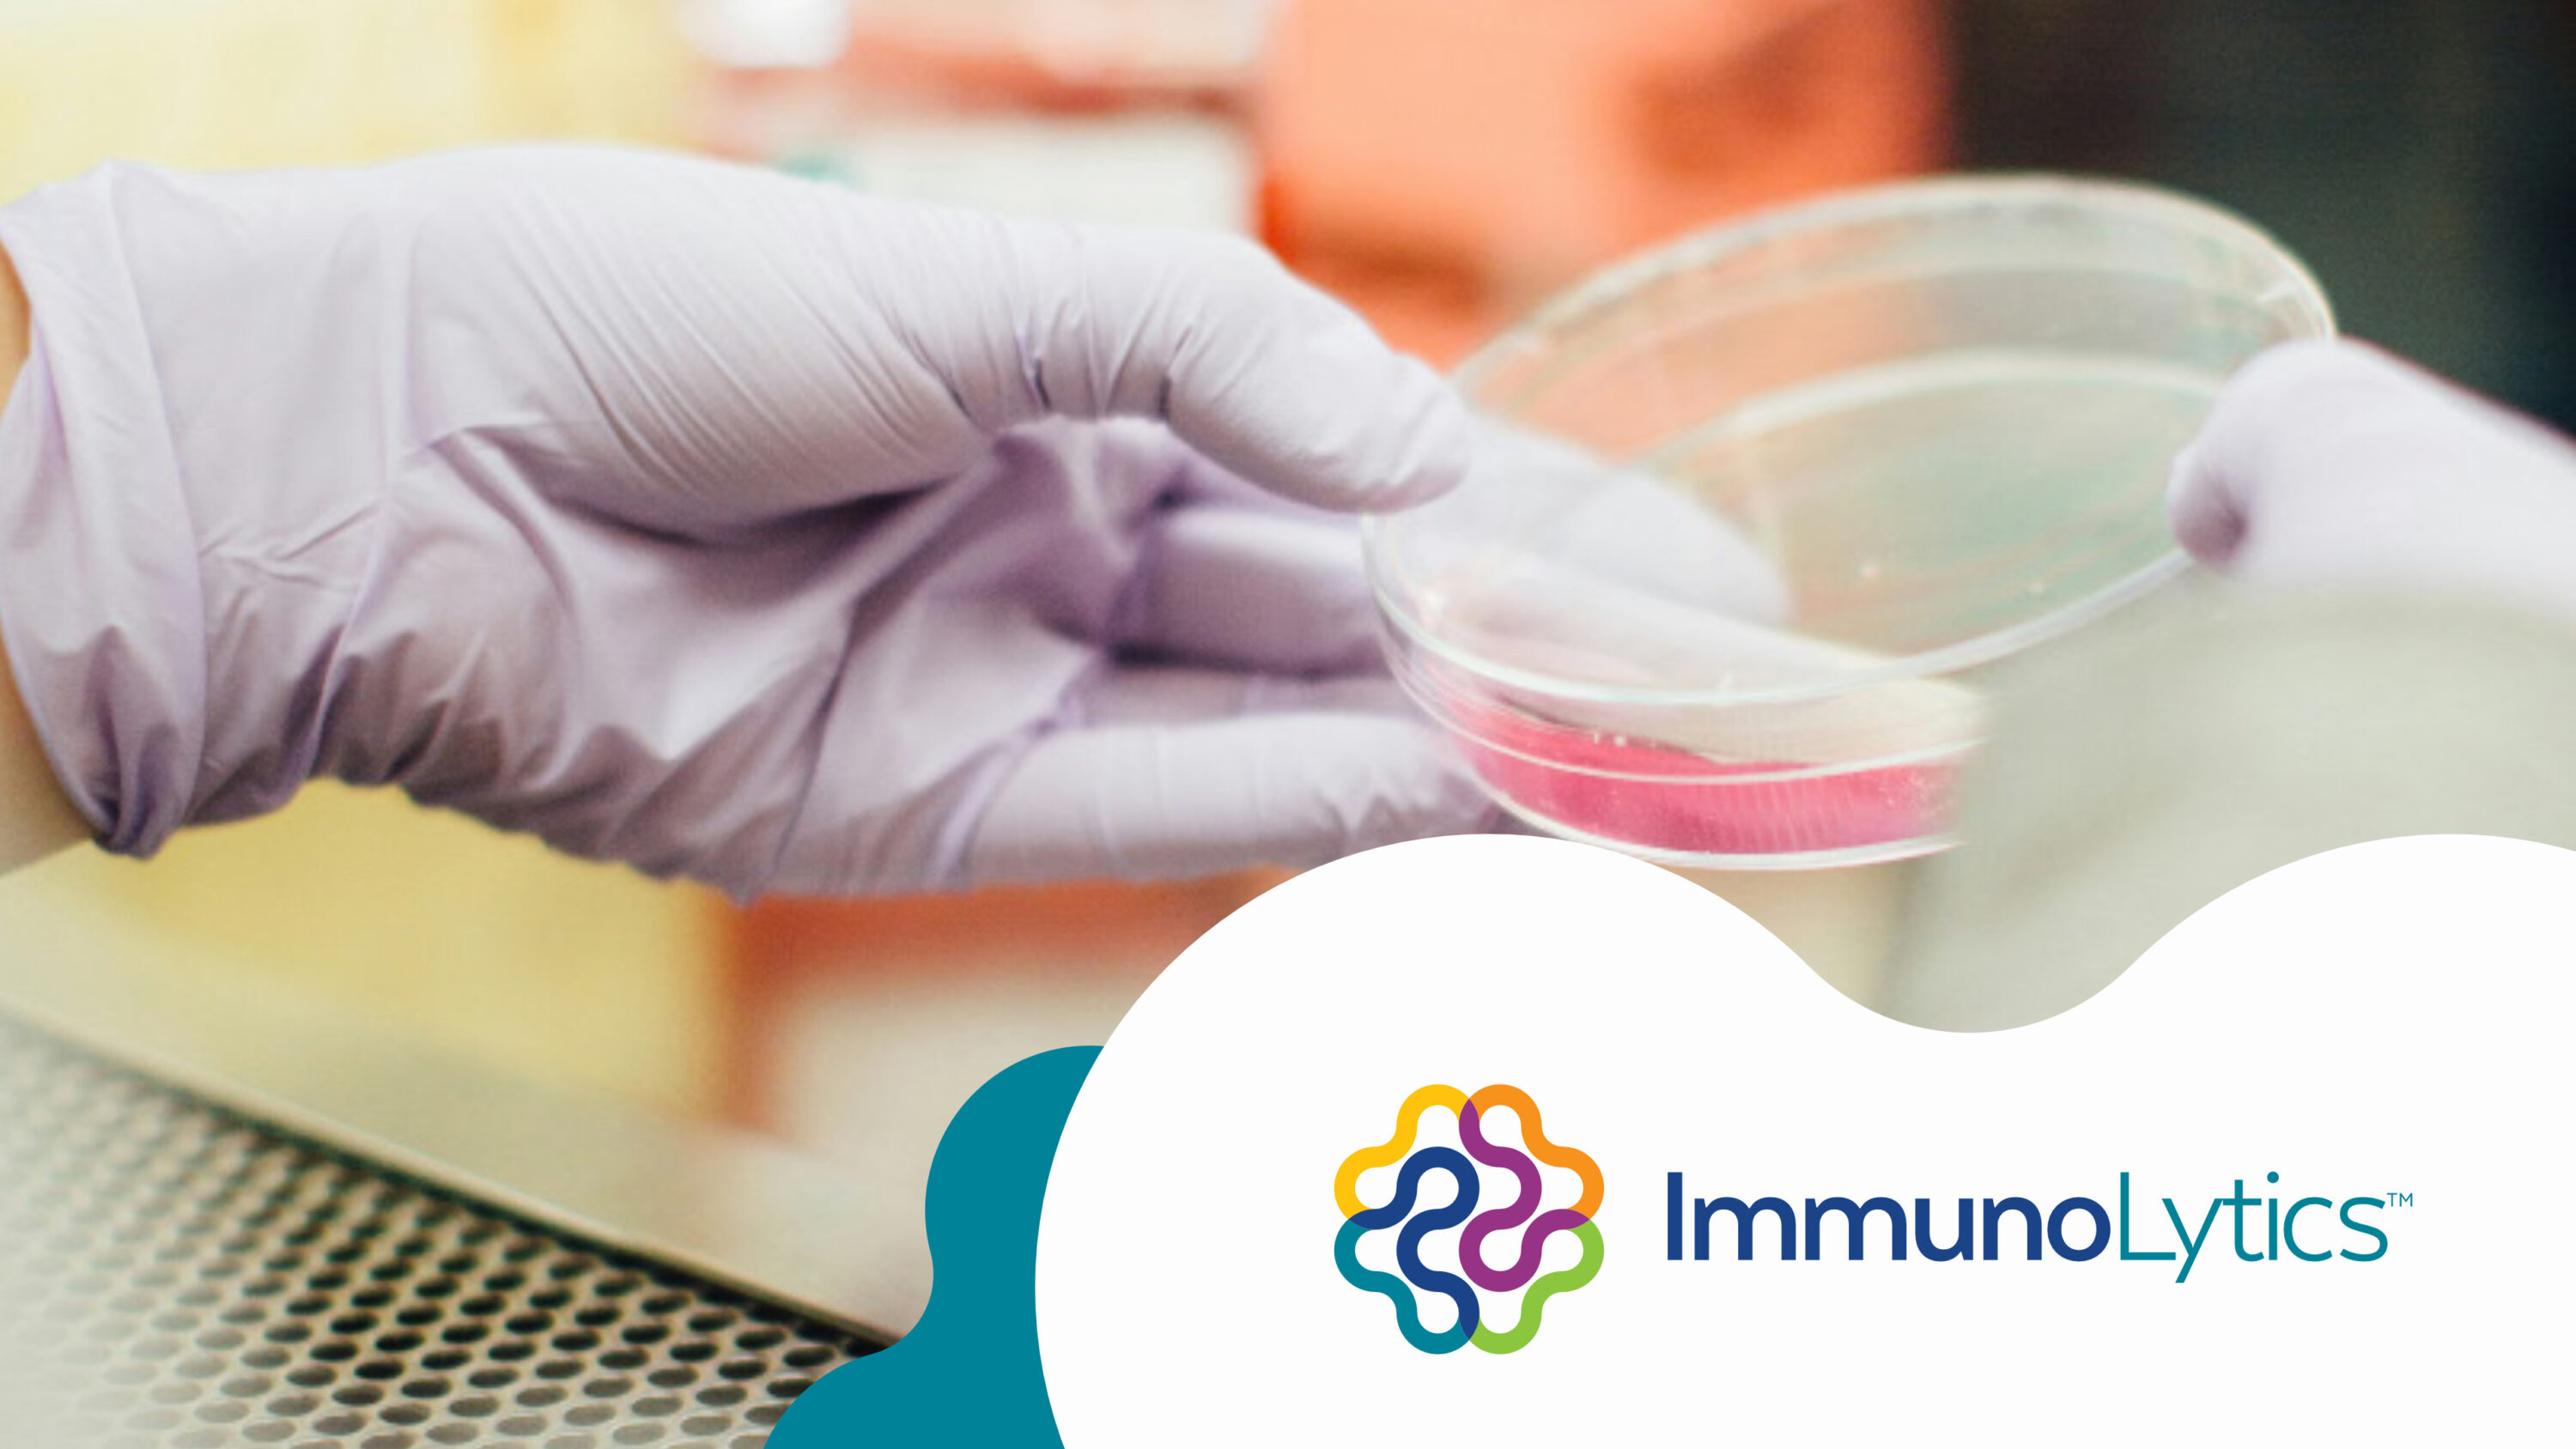

Our work
Work we’ve done for some folks we really like.
Brezza Tirrena
CitriSafe

RioSol Energy
Brand identity, strategy & marketing for a clean energy company.

SunZia Transmission
Brand identity, marketing and vision video for energy company.

Blue Stone Strategy Partners
Brand identity & integrated marketing for a tribal consultancy.

Helse Ultrasonic
Brand identity, strategy & marketing for dental products.
ImmunoLytics
Brand identity & integrated marketing for mycology lab.

Sunset Mesa School
Brand identity & integrated marketing for private school.
